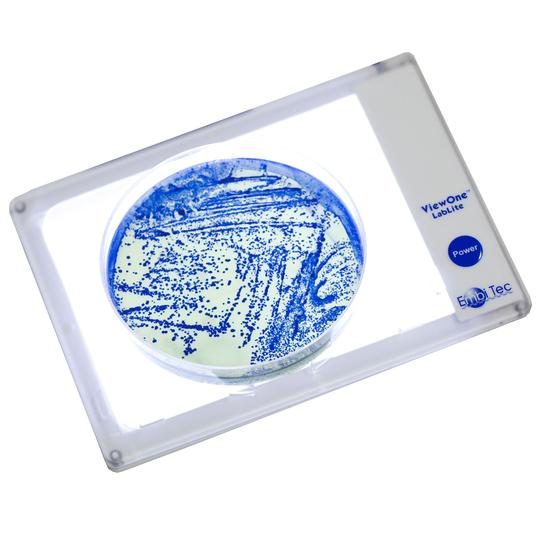
图片标题

| 产品名称:LIGHTONE? 移液追踪器,LIGHTONE? PIPETTING TRACKERS |
| 品牌:美国embi |
| 货号:LIGHTONE |
| 价格:询价 |
| 联系人:李先生 |
| 电话:18618101725 |
LIGHTONE? 移液追踪器使用 LIGHTONE 吸取正确的!
跟踪移液位置 LED 按孔、按行或整个板照亮您的样品。跟踪移液、标记和挑选您的样品,并准确加载您的板。 LightOne 照明器是完美的移液辅助工具。
尽量减少错误。 zui大限度地提高移液效率并减少代价高昂的错误。通过照亮特定的孔,可以减少操作人员的错误,增加对测定准备和结果的信心。 以的眼光看待您的样品。 防水、超紧凑的 ViewOne? LabLite 可以出色地照亮您的样品,并为您的成像系统或显微镜提供额外的背光。用于培养皿、琼脂板和 96 孔板的内置固定器可将您的样品固定到位。 更好的可视化: 96 孔 ELISA、384 孔板、基于凝胶的 PCR、淋巴结清扫、菌落挑选和细菌板、血凝测定、考马斯蓝染色凝胶、酶谱凝胶、细胞集落和细胞培养板。 小巧、轻便、便携。 仅比智能手机稍大 - 将它带到您的下一次会议或实地考察中!
|